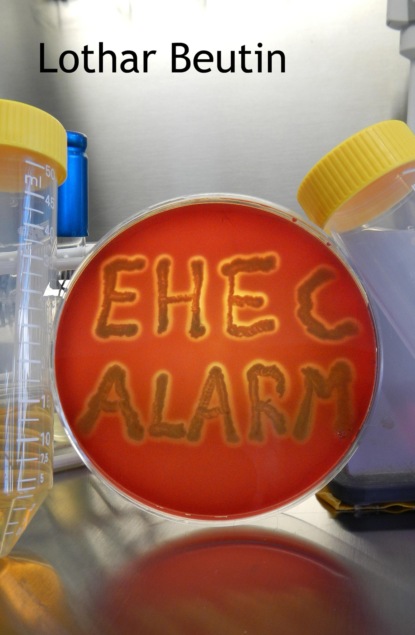
EHEC-Alarm

EHEC-Alarm
EHEC-Alarm ist ein Wissenschaftskrimi, der auf einer wahren Begebenheit basiert und der die als langweilig empfundene Welt der Mikrobiologie in einem sehr spannenden Licht erscheinen lässt. Als im Sommer 2011 in Norddeutschland plötzlich eine Seuche mit dem unbekannten Krankheitserreger EHEC O104 ausbricht, sind die Experten ratlos. Marie, eine Freundin des Kieler Mikrobiologiestudenten Harald Pütz, die auf einem Bauernhof lebt und sich streng vegetarisch ernährt, wird das erste Opfer der Seuche. Die Jagd nach dem EHEC-O104 und seiner Quelle beginnt, doch die schnelle Verbreitung des Bakteriums lässt den Forschern keine Atempause und bringt das Gesundheitssystem an den Rand des Zusammenbruchs. In wenigen Wochen erkranken über 4000 Menschen, 800 erleiden schwere Nierenschäden und auffällig häufig sterben junge Frauen an der Seuche. Der Mikrobiologe Leo Schneider am Berliner Institut für Lebensmittelkontrolle und Hygiene ist beauftragt, die Quelle des Erregers zu finden. Dabei führt Schneider einen aussichtslos erscheinenden Kampf gegen ein erbarmungsloses Kartell aus ignoranten Bürokraten, machtbesessenen Politikern und skrupellosen Kollegen, denen aus unterschiedlichen Gründen sehr daran gelegen ist, den wahren Hintergrund der EHEC-O104 Seuche im Dunkel zu halten. Um ihre Interessen durchzusetzen, schrecken Schneiders Gegner selbst vor Mord nicht zurück. Wie oft im Leben bestimmt manchmal mehr der Zufall als die Absicht über das Schicksal des Einzelnen in einem Gespinst aus Lüge, Täuschung und Verrat.